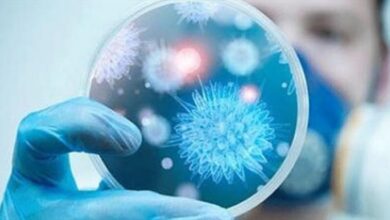

منوعات
-
يناير- 2026 -28 يناير

ميتا تتجه للاشتراكات المدفوعة وتطلق مزايا حصرية على واتساب وفيسبوك
زقور نيوز/بغداد تستعد شركة ميتا لإطلاق مرحلة جديدة في نموذج عمل منصاتها الرقمية، من خلال إدخال نظام اشتراكات مدفوعة على…
أكمل القراءة » -
28 يناير

بشكل عاجل.. السلطات الصحية الامريكية تسحب كبسولات قهوة شائعة
زقورة نيوز/ بغداد حذّرت السلطات الصحية الأمريكية، من تداول كبسولات قهوة منزوعة الكافيين بعد اكتشاف احتمال احتوائها على مادة الكافيين،…
أكمل القراءة » -
28 يناير

قشور الإجاص تعزز صحة الأمعاء وتقيها من الالتهابات
زقورة نيوز/ متابعة كشفت دراسة طبية حديثة، وفق ما أوردته نتائج البحث، أن قشور الإجاص تحتوي على مواد قد تساعد…
أكمل القراءة » -
27 يناير

البلاستيك يهدد الصحة العالمية: أرقام صادمة تتوقع تضاعف الأضرار بحلول 2040
زقورة نيوز/متابعة حذّر تقرير علمي حديث من أن التأثيرات الصحية الضارة للبلاستيك قد تتضاعف على مستوى العالم بحلول عام 2040…
أكمل القراءة » -
27 يناير

الصين تدشن أول مصنع عالمي لإنتاج مفاصل الروبوتات الشبيهة بالإنسان
زقورة نيوز/متابعة أطلقت شركة Eyou Robot Technology الصينية أول مصنع في العالم مخصص لإنتاج مفاصل الروبوتات الشبيهة بالإنسان، في خطوة…
أكمل القراءة » -
26 يناير

ناسا تكشف عن “لمحة” مرعبة لمصير للشمس والأرض
زقورة نيوز/ متابعة كشفت وكالة ناسا النقاب عن لمحة مرعبة حول المصير المحتوم لنظامنا الشمسي من خلال رؤية نادرة لسديم…
أكمل القراءة » -
26 يناير

علماء يستخدمون الذكاء الاصطناعي لتصميم فيروس وظيفي
زقورة نيوز/ متابعة في تطور يعد نقلة نوعية في تاريخ العلوم البيولوجية، نجح فريق من جامعة ستانفورد الأميركية في توظيف…
أكمل القراءة » -
26 يناير
“نيباه” يدخل مطارات آسيوية بحالة انذار
زقورة نيوز/ متابعة بدأت مطارات متفرقة في أنحاء آسيا، بتشديد إجراءات المراقبة الصحية وفحص المسافرين بعد تفشي فيروس “نيباه” في…
أكمل القراءة » -
26 يناير

خابي يبيع صورة وجهه بنحو مليار دولار
زقورة نيوز/متابعة سجّل نجم تيك توك الأشهر خابي لام صفقة تجارية تاريخية قُدّرت قيمتها بنحو 900 مليون دولار، في واحدة…
أكمل القراءة » -
25 يناير

“قاتل وينتقل عن طريق الخفافيش”.. فيروس جديد يداهم الهند ومخاوف من انتشاره حول العالم
زقورة نيوز/ متابعة بدأ فريق من المعهد الوطني للبحوث الطبية في الهند بإجراء فحوص على خفافيش الثعالب الطائرة في حديقة…
أكمل القراءة »